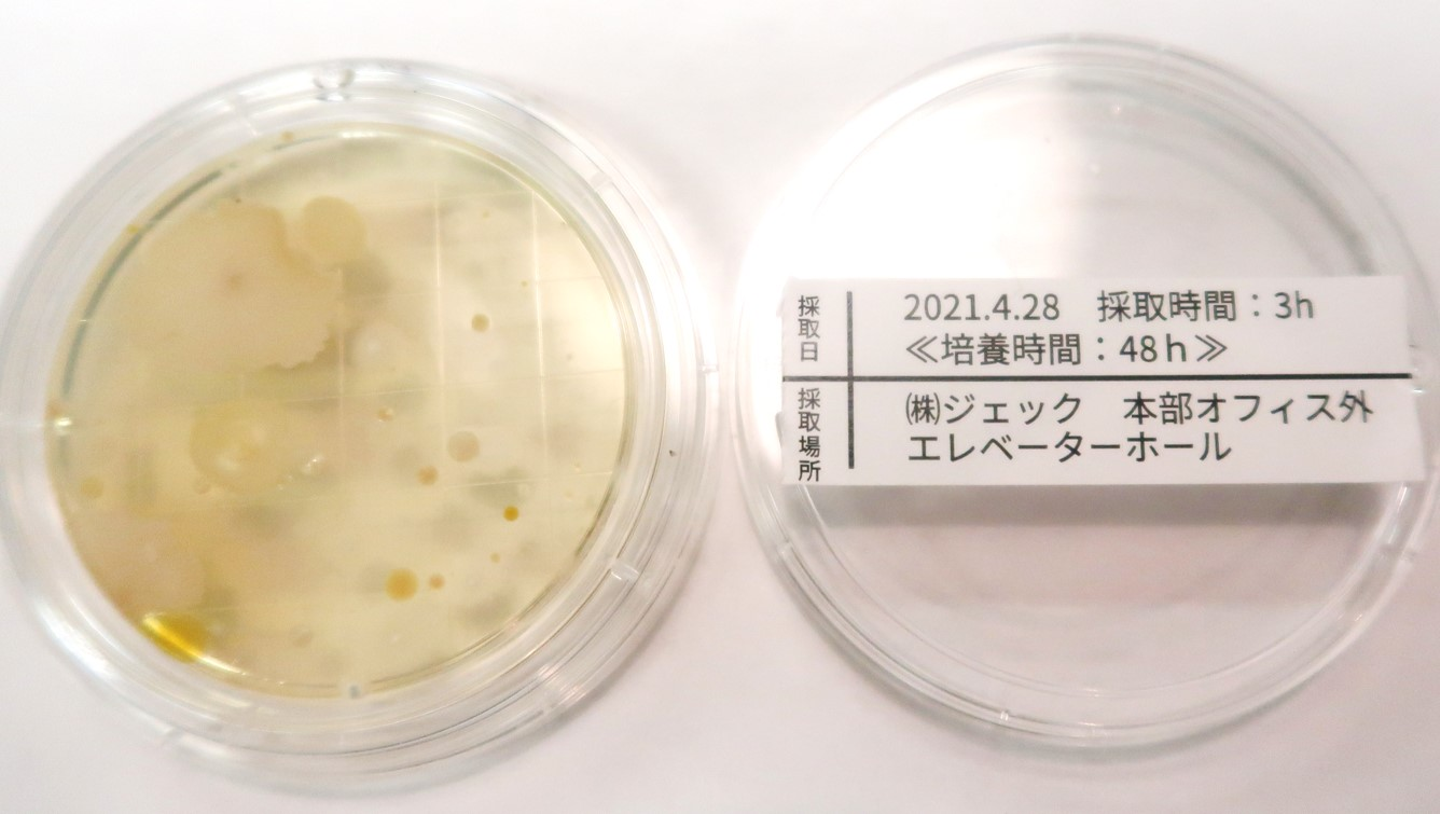

こんにちわ!株式会社ジェックの採用担当、荻原です!
今日は、先日ご紹介した実験の続きをご紹介したいと思います。
弊社の抗菌サービス事業「EZ BARRIER事業部」では、空間全体を抗菌するサービスも提供しています。
室内壁面緑化や人工樹木に抗菌コートを行うことで、そのグリーンが置かれた空間全体を抗菌することができるというこのサービス。
前回は抗菌コートについてのご紹介でしたが、今回は実際にどの程度効果があるのかを測定してまいりました!
▼どうやって測定するのか?▼
まずは、キレイを保ちたい空間に、抗菌コートされたフェイクグリーンを設置します。
弊社では、本部オフィスにいくつかの人工樹木やグリーンウォールのサンプルを置いているので、今回はここ本部オフィスで実験しました。
オフィス内のいくつかの場所に寒天培地を設置し、その場所の菌数を測定します。
![]()
今回はグリーンを置いていない「オフィスの部屋の外(エレベーターホール)」と、グリーンを置いている「オフィスの部屋の中(出入口付近)」の2カ所を比べたいと思います!
▼測定結果は…?▼
早速、測定結果を見てみましょう!
↓ まずは、グリーンを置いていないエレベーターホールです。 ↓
![]()
おお…屋外から最初に入るだけの場所はありますね…。しっかりと、コロニー(菌の集落)が発生しています。私もいつも菌を付着させて出社しているんでしょうか…?このように目に見えると、ちょっとゾッとしますね。
では、続けてグリーンを置いているオフィス内です。
オフィス内とはいえ、先ほどのエレベーターホールと扉一枚隔てているだけ。しかもオフィス自体の出入口はここだけなので、人の出入りも多い場所です。
本当に菌を不活性化できているのでしょうか…?
↓ オフィス内の結果はコチラ! ↓
![]()
す、すごい…!肉眼ではほぼ確認できないほどです。
ふとした小休憩のときに眺めていたグリーン達、見た目で癒してくれるだけじゃなく、しっかり菌やウイルスからも守ってくれていたんだ~!と改めて実感いたしました。しっかりと抗菌コートの効果が発揮されていることが証明されましたね!
このようにEZ BARRIER事業部では、空間を装飾するためのグリーンに抗菌コートを施すことで、
装飾した空間全体も抗菌化するというサービスをご提案をしております。
まだまだ立ち上がったばかりの新規事業のため、一緒に事業を拡大してくれるメンバーを募集中です!
人が安心して集まることができる空間を、一緒に広めていきませんか?
少しでも興味がありましたら、まずはお話を聞きに来てください!
お会いできることを楽しみにしております!
株式会社ジェック's job postings

/assets/images/145615/original/cf77de64-d20b-49b3-a0b1-7343b288e79f.jpeg?1434878144)
/assets/images/145615/original/cf77de64-d20b-49b3-a0b1-7343b288e79f.jpeg?1434878144)

